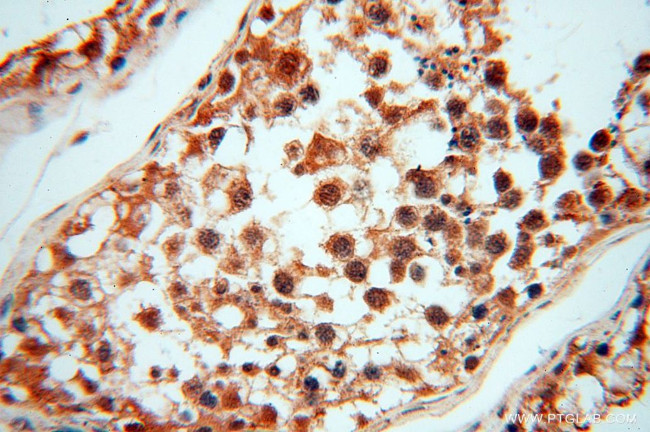
CNBP Antibody in Immunohistochemistry (Paraffin) (IHC (P))

Search
Proteintech
CNBP Polyclonal Antibody
{{$productOrderCtrl.translations['antibody.pdp.commerceCard.promotion.promotions']}}
{{$productOrderCtrl.translations['antibody.pdp.commerceCard.promotion.viewpromo']}}
{{$productOrderCtrl.translations['antibody.pdp.commerceCard.promotion.promocode']}}: {{promo.promoCode}} {{promo.promoTitle}} {{promo.promoDescription}}. {{$productOrderCtrl.translations['antibody.pdp.commerceCard.promotion.learnmore']}}
产品信息
14717-1-AP
种属反应
已发表种属
宿主/亚型
分类
类型
抗原
偶联物
形式
浓度
规格
纯化类型
保存液
内含物
保存条件
运输条件
产品详细信息
Immunogen sequence: MSSNECFKC GRSGHWAREC PTGGGRGRGM RSRGRGFQFV SSSLPDICYR CGESGHLAKD CDLQEDACYN CGRGGHIAKD CKEPKREREQ CCYNCGKPGH LARDCDHADE QKCYSCGEFG HIQKDCTKVK CYRCGETGHV AINCSKTSEV NCYRCGESGH LARECTIEAT A (1-170 aa encoded by BC000288)
靶标信息
This gene encodes a nucleic-acid binding protein with seven zinc-finger domains. The protein has a preference for binding single stranded DNA and RNA. The protein functions in cap-independent translation of ornithine decarboxylase mRNA, and may also function in sterol-mediated transcriptional regulation. A CCTG expansion in the first intron of this gene results in myotonic dystrophy type 2. Multiple transcript variants encoding different isoforms have been found for this gene.
仅用于科研。不用于诊断过程。未经明确授权不得转售。
生物信息学
蛋白别名: CCHC-type zinc finger nucleic acid binding protein; cellular nucleic acid binding protein 1; Cellular nucleic acid-binding protein; CNBP; erythroid differentiation-related; HGNC:13164; sterol regulatory element-binding protein; unnamed protein product; zinc finger protein; zinc finger protein 273; Zinc finger protein 9; zinc finger protein 9 (a cellular retroviral nucleic acid binding protein); zinc finger protein; hCNBP
基因别名: AA408710; CNBP; CNBP1; DM2; PROMM; RNF163; ZCCHC22; ZNF9
UniProt ID: (Human) P62633, (Mouse) P53996
Entrez Gene ID: (Human) 7555, (Mouse) 12785